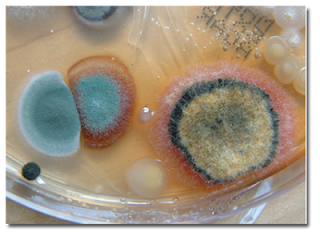

Επαγγελματικός Οδηγός Ιωαννίνων
Το Blog του Επαγγελματικού Οδηγού Ιωαννίνων
Μούχλα, στο ψυγείο, στο μπάνιο, στο στρώμα, στα ρούχα. Ποιοι κινδυνεύουν πιο πολύ; Πώς αντιμετωπίζεται
Μούχλα είναι η κοινή ονομασία για πολλούς και διαφορετικούς μύκητες, που αναπτύσσονται σε οργανικές ουσίες, οι οποίες βρίσκονται σε αποσύνθεση και έχουν μια χαρακτηριστική μυρωδιά, είναι συνήθως άχρωμη και συνήθως δεν είναι ορατό με γυμνό μάτι στην φάση της δημιουργίας της.
Για τον πολλαπλασιασμό και τη διάδοση της βοηθούν μικροσωματίδια. Αυτά έχουν χρώματα και σε αυτό το στάδιο γίνεται ορατή με γυμνό μάτι ως μαύρη ή κίτρινη κηλίδα. Πως προκύπτει η μούχλα; Σε εσωτερικούς χώρους, η επώαση της μούχλας προκαλείται ιδιαίτερα λόγω τριών παραγόντων: υγρασία, θρεπτικά συστατικά και θερμοκρασία. Τα θρεπτικά συστατικά στο σπίτι και στο διαμέρισμα είναι πολλά. Οι μύκητες εγκαθίστανται σε...
ξύλα και γυψοσανίδες ή τρέφονται από ταπετσαρίες, χρώματα, βερνίκια, σιλικόνη, κόλλες δαπέδων, δέρμα και πολλά άλλα υλικά. Σε περίπτωση υλικών με υψηλή τιμή pH η επώαση περιορίζεται. Η μούχλα αναπτύσσεται όμως και σε υλικά που δεν προσφέρουν από μόνα τους θρεπτικές ουσίες, όταν έχουν πάνω τους οργανικά σωματίδια και ρύπους, για παράδειγμα το κεραμικό και το γυαλί. Η επώαση είναι δυνατή μόνο με την παρουσία υγρασίας.
Αναπαράγεται με σπόρια και χρειάζεται τροφή από εξωτερικές πηγές, γιατί δεν περιέχει χλωροφύλλη.
Γίνεται ορατή όταν αναπτύσσεται σε μεγάλες συγκεντρώσεις.
Προϋποθέσεις για την ανάπτυξη αυτών των μεγάλων συγκεντρώσεων είναι:
- Να υπάρχει αυξημένη υγρασία είτε σαν εσωτερική σχετική υγρασία ή σαν υγρασία που μπαίνει μέσα στο σπίτι από υπόγεια ή ατέλειες στους τοίχους και στο δώμα, σαν υγρασία από μόνιμες μικροδιαρροές λόγω αστοχίας των υδραυλικών συστημάτων είτε, τέλος, σαν υγρασία λόγω πλημμύρας.
- Να υπάρχει οργανική ύλη για να μπορεί να τραφεί.
- Να υπάρχει σχετική έλλειψη αερισμού.
- Να υπάρχει αρκετή βρομιά που υποβοηθά την ανάπτυξη της μούχλας δίνοντάς της κατάλυμα και τροφή.
- Να υπάρχουν ταπετσαρίες σε αμόνωτους τοίχους, χαλιά και μοκέτες σε υπόγεια και υφασμάτινα πατάκια σε υγρούς χώρους όπως τα μπάνια.
- Υποθερμασμένοι εξωτερικοί τοίχοι ή υποθερμασμένα δωμάτια και χώροι (υποβοηθούν τη συμπύκνωση).
- Στην εμφάνιση της "μούχλας" στις γωνίες των ταβανιών υπεύθυνες θεωρούνται οι "θερμογέφυρες" (αμόνωτα κομμάτια μπετόν που είναι ψυχρότερα από τον υπόλοιπο τοίχο) και εκεί πάνε και "κάθονται" οι υδρατμοί και υγροποιούνται, με αποτέλεσμα να μαυρίζει το μέρος αυτό.
- Το σκοτάδι βοηθάει την ανάπτυξη μούχλας, γιατί ευνοεί την διατήρηση της υγρασίας. Όχι όμως ότι η μούχλα δεν αναπτύσσεται στο φως.
Τι προκαλεί η μούχλα
Οι συχνότερες διαταραχές υγείας που προκαλούνται, εξαιτίας της μούχλας στους εσωτερικούς χώρους, είναι κυρίως οι αλλεργίες και αναπνευστικές παθήσεις. Υπάρχουν εκατοντάδες χιλιάδες διαφορετικά είδη μούχλας, αλλά μόνον δέκα από αυτά προκαλούν προβλήματα υγείας – συνήθως ασθματικές κρίσεις, ιγμορίτιδα, βρογχίτιδα και άλλα νοσήματα των πνευμόνων, καθώς και αλλεργικές αντιδράσεις.
Η μούχλα απειλεί περισσότερο την υγεία των κατωτέρω ομάδων ανθρώπων:
– όσοι υποφέρουν από άσθμα και άλλες ασθένειες του αναπνευστικού
– όσοι είναι ανοσοκατασταλμένοι
– οι άνθρωποι μεγάλης ηλικίας & τα βρέφη, νήπια και γενικά τα παιδιά προσχολικής ηλικίας.
Οι πιθανές ενδείξεις πως υπάρχει πρόβλημα με μούχλα στο σπίτι συμπεριλαμβάνουν βήχα, συνεχή κόπωση, ερεθισμό των ματιών και του λαιμού, πονοκεφάλους, δερματικούς ερεθισμούς και ναυτία.
Τα σπόρια από κάποιες μούχλες (π.χ. Ασπέργιλος flavus, αφρικάνικος ασπέργιλος κτλ.) είναι εξαιρετικά τοξικά, υπήρξαν δε, υπεύθυνα για πολλούς θανάτους, με πιο γνωστό αυτούς των αρχαιολόγων στον Τάφο του Φαραώ. Τότε επειδή η αιτία ήταν άγνωστη, τους απέδωσαν στην κατάρα του Φαραώ.
Οι ισχυρότατα τοξικές και καρκινογόνες αφλατοξίνες παράγονται από μούχλα που αναπτύσσεται κυρίως σε ξηρά φρούτα, ξηρούς καρπούς (ιδιαίτερα στα αράπικα φυστίκια και αμύγδαλα), μπαχαρικά, σιτηρά και σε τυριά όταν υπάρξουν κατάλληλες συνθήκες υγρασίας και θερμοκρασίας. Επίσης μπορεί να εμφανισθούν στο γάλα ζώων που έχουν τραφεί με ζωοτροφές (καλαμπόκι κ.λπ.), στα οποία είχαν αναπτυχθεί μύκητες.
Στους πάσχοντες από άσθμα ο μύκητας της ασπεργίλλωσης μπορεί να προκαλέσει βήχα και συριγμό, ενώ σε άτομα με αποδυναμωμένο ανοσοποιητικό σύστημα, όπως οι καρκινοπαθείς που υποβάλλονται σε χημειοθεραπεία, οι πάσχοντες από AIDS και τα άτομα που έχουν αυτό-άνοσα νοσήματα, κινδυνεύουν περισσότερο να εκδηλώσουν ασπεργίλλωση. Η ασπεργίλλωση προσβάλλει κυρίως ανοσοκατεσταλμένα άτομα, άτομα με κοκκιοκυτταροπενία, οξεία λευχαιμία, ή λέμφωμα. Χτυπά συνήθως τους πνεύμονες (90%), αλλά δεν αποκλείεται να επεκταθεί σε άλλα όργανα. Οι ασθενείς εμφανίζουν βήχα, πλευρωδυνία, πυρετό, δύσπνοια και ταχύπνοια.
Παράγοντες που συντηρούν και επιτείνουν το πρόβλημα της μούχλας στα σπίτια:
1) Η ύπαρξη οργανικής ύλης που της παρέχει τροφή: ρητίνες των χρωμάτων, φυσικές ίνες, χαρτί, ξύλο κλπ.
2) Βρωμιά, σκόνη, ίχνη από λίπη κλπ.
3) Σχετικά υψηλές θερμοκρασίες: ≥ 24 – 25ο C.
4) Η υγρασία. Μπορεί να προέρχεται από πολλές πηγές και μάλιστα μη προφανείς.
Η μούχλα στα σπίτια εντοπίζεται κυρίως:
1) Πάνω σε κρύα, αμόνωτα δομικά στοιχεία του εξωτερικού περιβλήματος.
(δοκάρια τοιχεία, κολόνες κλπ. Είναι οι γνωστές θερμογέφυρες).
2) Σε δωμάτια με μεγάλη σχετική υγρασία ιδιαίτερα όταν στερούνται μηχανικού εξαερισμού
(μπάνια κουζίνες, πλυσταριά κλπ
3) Σε υπόγειους χώρους.
Η μούχλα χρειάζεται μεν οξυγόνο αλλά όχι και φως, γιατί δεν περιέχει χλωροφύλλη και συνεπώς δεν κάνει φωτοσύνθεση.
Τα υγρά υπόγεια αποτελούν ιδανικό περιβάλλον για την ανάπτυξη κι εξάπλωση της μούχλας.
4) Μέσα σε ντουλάπες που είναι σε επαφή με το εξωτερικό περίβλημα του σπιτιού.
5) Πίσω από έπιπλα που βρίσκονται κοντά στο εξωτερικό περίβλημα του σπιτιού.
Προληπτικά και θεραπευτικά μέτρα κατά της μούχλας
– Οι μεγαλύτεροι εχθροί της μούχλας είναι η καθαριότητα (συμπεριλαμβάνει και τον καλό αερισμό) και η έλλειψη υγρασίας.
Σαφώς και δεν μπορούμε να βγάλουμε την οργανική ύλη – που αποτελεί τροφή για τη μούχλα – έξω από τα σπίτια.
Τα προληπτικά και τα θεραπευτικά μέτρα πολλές φορές αλληλοεπικαλύπτονται γι’ αυτό θα παρατεθούν χωρίς διαχωρισμό:
1) Αποτροπή συμπυκνώσεων
– Όλοι οι σωλήνες κρύου νερού πρέπει να θερμομονώνονται με τα κατάλληλα υλικά.
– Οι θερμογέφυρες πρέπει να αποφεύγονται κατά το δυνατόν.
Εάν υπάρχουν, πρέπει:
– Να θερμομονώνονται εκ των υστέρων
– Να βάφονται με ειδικές αντισυμπυκνωτικές βαφές (τύπου Dip Αnticondensation).
* ή τουλάχιστον να βάφονται με αντιμηκυτικά χρώματα (θα υπάρχει συμπύκνωση αλλά όχι μούχλα).
2) Άμεσος εντοπισμός και επιδιόρθωση βλαβών στα υδραυλικά δίκτυα.
Οι βλάβες αυτές είναι υπεύθυνες για πολλές και κυρίως μεγάλου βεληνεκούς ζημίες από τη μούχλα.
3) Τακτικός αερισμός
Ο αερισμός διαλύει και απομακρύνει τα μεγάλα φορτία υδρατμών.
Πρέπει να υπάρχει κυκλοφορία του αέρα σε όλα τα ύποπτα για ανάπτυξη μούχλας σημεία όπως π.χ. πίσω από τα έπιπλα.
Το μόνιμο άνοιγμα ενός κουφώματος έστω και κατά 0,5cm βοηθάει προς αυτή την κατεύθυνση.
Μπορεί ο εξωτερικός χειμωνιάτικος αέρας να έχει υψηλή σχετική υγρασία, αλλά οι απόλυτές του τιμές είναι χαμηλές.
Όταν μπαίνει μέσα στο σπίτι, η σχετική του υγρασία πέφτει πολύ συμπαρασύροντας προς τα κάτω τη συνολική εσωτερική σχετική υγρασία.
4) Μείωση και εξορθολογισμός της παραγωγής υδρατμών
Οι υδρατμοί παράγονται κυρίως από τις εξής ανθρώπινες δραστηριότητες:
α) Μπάνια και κυρίως ντουζ.
β) Μαγείρεμα.
γ) Πότισμα εσωτερικών φυτών (περιορίστε τα).
δ) Στέγνωμα ρούχων κλπ. (κόψτε αυτή τη συνήθεια).
Τα μπάνια και οι κουζίνες πρέπει να έχουν μηχανικό εξαερισμό.
Δεν πρέπει να γίνεται άσκοπη χρήση υγραντήρων.
5) Εντοπισμός εισροής νερού σε δώματα, τοίχους και υπόγεια και άμεση αντιμετώπισή της
Το νερό μπορεί να μπαίνει σε υγρή αλλά και σε αέρια μορφή (υδρατμοί) π.χ. μέσω διάχυσης, μεταφοράς αέριων μαζών από τρύπες και ανοίγματα κλπ.
6) Καθαρισμός επιφανειών – Απόρριψη προσβεβλημένων αντικειμένων
Κάθε επιφάνεια χρειάζεται κατάλληλα καθαριστικά μέτρα και υλικά.
Τα συνηθέστερα καθαριστικά μέσα είναι:
α) Εξειδικευμένα μυκητοκτόνα όπως π.χ. το Antimousse.
Είναι προτιμότερα γιατί είναι εύκολα στη χρήση και δεν αφήνουν υπολείμματα.
Για δουλειές μικρού βεληνεκούς είναι η δέουσα λύση.
β) Χλωρίνη (υποχλωριώδες νάτριο 5%). Αραιώστε τη με νερό: ένα ποτήρι σε 3-4 κιλά νερό.
Τα υπολείμματά της πρέπει να απομακρύνονται.
Κοινά απορρυπαντικά (χωρίς όμως αμμωνία) ή φωσφορικό νάτριο (Νa3PO4) μπορούν να προστεθούν στο μίγμα ανάλογα με την τελική του χρήση.
Αντικείμενα που δεν επιδέχονται στεγνώματος και καθαρισμού πρέπει να απορρίπτονται, γιατί αποτελούν εστία περαιτέρω μόλυνσης.
Στο ψυγείο
Πολλά προϊόντα μουχλιάζουν ή χαλάνε μετά από αρκετό καιρό στο ψυγείο. Ποια είναι όμως εκείνα που μπορούμε να κρατήσουμε και ποια πρέπει να πετάξουμε επειγόντως, αφού μπορεί να βλάψουν την υγεία μας;
Τα σκληρά τυριά όπως το τσένταρ είναι κλασικές περιπτώσεις όπου μπορείτε να αγνοήσετε τη μούχλα – απλά κόψτε την, το εσωτερικό παραμένει φαγώσιμο· όπως και με το ψωμί.
Ωστόσο, αυτό δεν ισχύει με τα μαλακά τυριά όπως το μπρι ή το καμαμπέρ, τα οποία μπορεί να γίνουν κατοικία επικίνδυνων βακτηρίων άπαξ και χάσουν τη φρεσκάδα τους.
Το ίδιο ισχύει και για τα λαχανικά και το σκληρό σαλάμι.
Αν η μούχλα έχει εξαπλωθεί σε τροφές όπως τα κονσερβοποιημένα κρέατα, το μαγειρεμένο κρέας και τα πουλερικά, τα μαγειρεμένα φαγητά κατσαρόλας, το γιαούρτι, τις μαρμελάδες, το ψωμί ή τα παξιμάδια, τότε πετάξτε τα.
Στο στρώμα
Στις οδηγίες των στρωμάτων θα διαβάσετε ότι το στρώμα απαγορεύεται να βραχεί ή να πλυθεί, αλλά και να αποφεύγετε τον καθαρισμό με τη χρήση ατμού, διότι θα δημιουργηθεί στο εσωτερικό του στρώματος υγρασία και μούχλα!
Αν βάλετε χλωρίνη, μαγειρική σόδα, η σόδα με οδοντόπαστα, ακόμα και ζάχαρη, που αναφέρονται σε διάφορα άρθρα, η κατάσταση θα επιδεινωθεί.
Εάν υπάρχει μούχλα που υπάρχει στο στρώμα , υπάρχει μια πιθανότητα ότι η μούχλα να είναι σε ολόκληρο το δωμάτιο και θα πρέπει να αφαιρεθεί.
Στα ρούχα
Μην στεγνώνετε ρούχα μέσα στο σπίτι. Η μέθοδος αυτή κρύβει σοβαρότατους κινδύνους για την υγεία μας.
Τα ρούχα όταν στεγνώνουν πάνω σε θερμαντικά σώματα αυξάνουν τα επίπεδα υγρασίας στον χώρο κατά 30%, δημιουργώντας το ιδανικό περιβάλλον για την ανάπτυξη μούχλας.
Στεγνώνουμε τα ρούχα σε ανοιχτό χώρο η σε ειδικό στεγνωτήριο
– Αν δεν έχουμε εναλλακτική, φροντίζουμε, όταν το στέγνωμα γίνεται μέσα στο σπίτι, να μην πρόκειται για την κρεβατοκάμαρα ή το σαλόνι
– Σε κάθε περίπτωση έχουμε ανοιχτά παράθυρα
Μούχλα στο μπάνιο
– Ενώ κάνετε μπάνιο, ανοίξτε το παράθυρο. Αυτό που πρέπει να προσέξετε πολύ είναι η φορά του αέρα να είναι από μέσα προς τα έξω κι όχι το αντίθετο.– Μετά το μπάνιο σκουπίστε τις επιφάνειες.– Ψεκάστε το μπάνιο και το ντους αρκετά συχνά με ξύδι! Σταματά τον σχηματισμό της μούχλας.
– Όταν κάνετε μπάνιο, το πατάκι στο οποίο θα πατήσετε όταν βγείτε απορροφά νερό. Αυτό έχει ως αποτέλεσμα να κρατά υγρασία, γι” αυτό μόλις τελειώσετε βγάλτε το έξω να στεγνώσει.– Αν μπορείτε κι έχετε τη δυνατότητα εγκαταστήστε στο μπάνιο, αφυγραντήρα.
της Αγγελικής Μήλιου, βιολόγου, medlabnews.gr
Πηγή:epirus-tv-news.gr